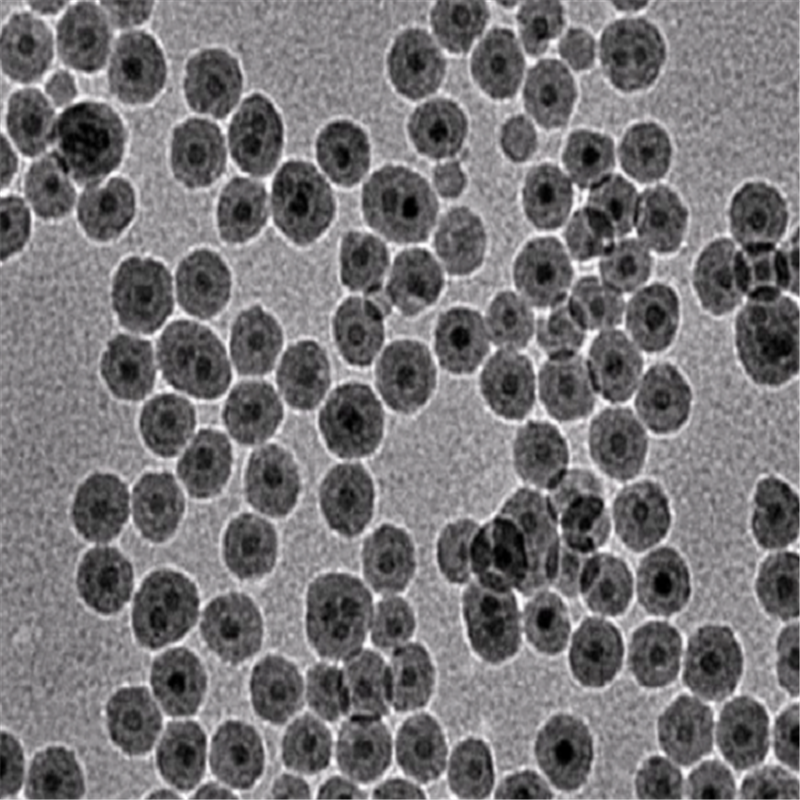

产品详情
羧基磁性纳米颗粒10nm
关于我们:
陕西星贝爱科生物科技经营的产品种类包括有:合成磷脂、高分子聚乙二醇衍生物、嵌段共聚物、磁性纳米颗粒、纳米金及纳米金棒、近红外荧光染料、活性荧光染料、荧光标记物、蛋白交联剂、小分子PEG衍生物、点击化学产品、树枝状聚合物、环糊精衍生物、大环配体类、荧光量子点、透明质酸衍生物、石墨烯或氧化石墨烯、碳纳米管、富勒烯,二氧化硅及介孔二氧化硅,聚合物微球,近红外荧光染料,聚苯乙烯微球,上转换纳米发光颗粒,MRI核磁造影产品,荧光蛋白及荧光探针等等。
温馨提示:仅用于科研,不能用于人体!
相关产品:
金纳米星
金纳米双锥
金纳米链
金纳米线
金纳米花
金纳米簇
柠檬酸钠修饰金纳米棒
银包金复合纳米颗粒
二氧化硅包覆金纳米颗粒
银纳米立方(CTAC包覆)
银纳米线
- 上一篇:磁性介孔二氧化硅纳米颗粒50nm
- 下一篇:中空介孔磁性纳米颗粒100nm